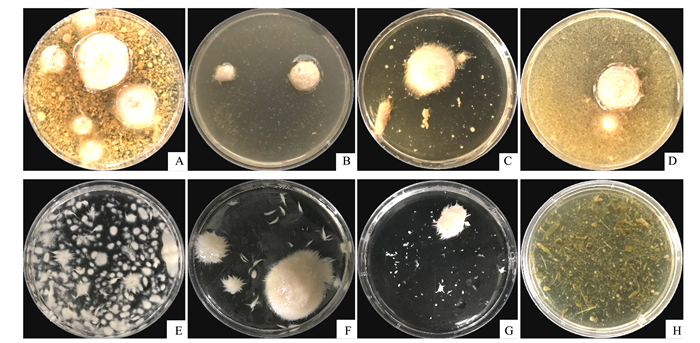
壳寡糖的促进生根作用,壳寡糖对免疫系统的调节作用

前言:
壳聚糖 是β-(1-4)-连接的N-乙酰基-2-氨基-2-脱氧-d-葡萄糖(乙酰化)和2-氨基-2-脱氧-d-葡萄糖(脱乙酰化)的 线性聚合物 。

我们发现壳聚糖能够诱导膜去极化并影响膜的完整性,通过1H-NMR的分析,观察到渗出物呈现出一种动态性,根系渗出物中检测到最多的信号。
用壳聚糖进行浇灌的植物的根系分泌物能够抑制番茄根寄生真菌尖孢镰刀菌的生长。

使用1%次氯酸钠对番茄种子进行表面灭菌处理后,用无菌蒸馏水(SDW)每分钟洗涤三次。
将番茄种子放置于发芽培养基(GM) ,其中包含葡萄糖10g L–1、酵母提取物0.1 g L–1、巴托普酮0.1 g L–1和工业琼脂12 g L–1。
把转基因平板与番茄种子放在一起,并将其置于4°
C下进行分层处理,持续2天,在相对湿度为65%(RH)的黑暗环境中孵育5天,在光周期为16小时光照和8小时黑暗的条件下再孵育5天。
然后将幼苗单独放置在装有甘伯格B5 1:10,将充满0.5M KCl(尖端直径<1μm)的玻璃微毛细管插入根皮质细胞,直到获得稳定的基础电位。

根暴露于浓度逐渐增加的壳聚糖中,在壳聚糖浓度的每次变化之
间,用Gamborgs B5 1:10替换根培养基,以检查细胞的生理
状态。

根部重要染色
将番茄幼苗置于Gamborgs B5 1:10液体培养基中适应环境,持续1天,在培养基中添加0.1、1和2 mg/mL的壳聚糖,作为对照组,只将幼苗置于Gamborgs B5 1:10中而不加入壳聚糖。
处理过的幼苗孵育24小时后,使用荧光素二乙酸酯(FDA)染色根部,先将根部放入稀释为250:20的*酮丙**溶液中,在磷酸盐缓冲盐水中使用显微镜10倍物镜和相机系统的落射荧光进行观察,未受损的细胞将显示绿色的FDA荧光, 而受损细胞核则会显示红色的PI荧光。

植物生长条件
将番茄幼苗(实验1)放置于200 mL的发泡聚苯乙烯无菌杯中,每个杯子含有100 cm3的消毒沙子,把它们置于培养室中, 温度为24°C,相对湿度为65% 。
光周期为16小时光照和8小时黑暗中,使用Gamborgs B20基础混合物与水按照5:1的比例灌溉植物,持续10天,并保持水分达到田间容量,取出植物后,进行洗涤并将其单独放入洋红色盒中。

每个处理进行3次生物学重复
将植物孵育1天,实验中收集的渗出物是经过累积超过3天的根系渗出物,可以使用1:10的Gamborgs B5基础混合物单独灌溉杯中的植物,或者使用0.1 mg/mL改良的脱乙酰壳多糖进行处理。
植物继续以相同的方式进行孵化,每个处理进行十次生物学重复,在种植后的第10、20和30天(dap),对根系分泌物进行取样,以进行进一步的分析, 实验中收集的渗出物是活性根系渗出物。

根系渗出物的收集
在实验中,收集在洋红色盒子中积累3天的根系分泌物,并通过Miracloth(Calbiochem)过滤,每个池用三种植物的渗出物制成,每次处理三个生物重复,根系渗出物池用0.22μm(Q-MAX)过滤并在-20°C下冷冻以备进一步使用。
另外,在实验中,去除整株植物,并使用SDW洗涤其根系, 将每克根使用20 mL SDW的无菌塑料容器中处理,收集来自这些植物的根系分泌物。

植物在24°C,相对湿度为65%的黑暗中孵育24小时,然后去除植物,通过使用10.0μm(Q-MAX)过滤器,收集来自22个生物重复的根系分泌物,并在-20°C下冷冻储存,以备后续使用。
发射激发矩阵 (EEM) 荧光分析
收集每种根系渗出物6500mL,并使用配备150W氙灯的分光荧光计获得激发发射矩阵(EEM)荧光光谱。
从全根分泌物(共220个样品)或池的水提取物中获取EEM荧光光谱的轮廓图,发射(Em)波长范围在5至220 nm之间,步长为5 nm,而激发(Ex)波长范围在2至350 nm之间,步长为1 nm。

使用1 nm的狭缝宽度,将根系分泌物置于路径长度为160 cm的熔融石英单元中,收集样品的紫外可见光谱,以 降低溶液的吸光度,消除潜在的内部过滤器效应 ,采用平行因子分析(PARAFAC)模型对根系分泌物的EEM荧光光谱进行分析,计算每个处理和时间点的成分。
植物激素分析
将根系渗出物池进行冻干处理,并使用 超高效液相色谱 -质谱联用法对吲哚乙酸(IAA)、脱落酸(ABA)、水杨酸(SA)和茉莉酸(JA)进行分析,材料使用80%甲醇-1%乙酸进行提取,并使用氘标记的激素,对于茉莉酸(JA)的定量分析,使用dhJA代替。

用于收集含有SA、ABA和JA的馏分,提取物通过HLB(反相)、MCX(阳离子交换)和WAX(离子交换)柱进行连续处理,最终残留物被溶解在5%*腈乙**-1%乙酸中,并通过反相UPLC色谱法进行分析,*腈乙**梯度范围为5%至50%。

植物褪黑激素检测
对植物的渗出物和组织进行了褪黑激素的测试,对于每种处理,使用壳聚糖(0.1、1、2mg mL–1)作为植物对照, 将0.2-0.3g的根部干燥在无菌纸上,然后放入含有4mL乙酸乙酯的3 mL聚丙烯管中。

样品在4°C的黑暗中以120rpm的速度摇匀过夜,去除根部后,在真空下蒸发溶剂,将得到的干燥残留物重悬于1mL*腈乙**中,并通过0.22μm的过滤器进行过滤。
来自根组织的植物褪黑激素通过HPLC进行定量,荧光检测使用280/348 nm的激发/发射波长配对,对于根系分泌物,使用实验1中的三个生物学重复中的1mL样品。

为了评估根系分泌物对根结线虫卵的影响,将200μl的渗出液或水(作为对照)与含有100个
爪哇分枝杆菌卵的培养基进行实验, 在72°C下孵育30小时后,使用倒置显微镜对孵化百分比
进行评分, 所有实验均进行了两次,结果相似。

壳聚糖使质膜去极化并降低番茄根细胞活力
壳聚糖(1 和 2 毫克毫升–1)去极化了番茄根细胞的质膜(p < 0.001),导致细胞活力的丧失,使用 2 mg mL 壳聚糖孵育的根部显示出弯曲的形态和深色沉淀,相反,低剂量的壳聚糖(0.1mg mL–1)对质膜电位没有影响。

然而,这些根部显示出活细胞(FDA绿色染色)和非活细胞,表明壳聚糖对细胞造成了一定
程度的损伤,未经处理的番茄根部显示大部分活细胞,在FDA染色下呈轻微的红色染色, 这
是由根表皮细胞引起的。

壳聚糖诱导根系分泌物中的激素和酚类化合物
根据荧光分析,激发发射基质根系分泌物可以被分为三个成分,其中,壳聚糖对组分1和2的诱导效果最显著(p < 0.01), 这些组分包括一个被推测的荧光团,其激发(Ex)/发射(Em)波长对为315/430nm,组分2的Ex/Em波长对为245/384和265/384nm,可能对应于芳香族氨基酸和肽。

在番茄根系分泌物中,壳聚糖可以诱导其他激素的积累,高剂量的壳聚糖(1和2毫克毫升–1)诱导了IAA(吲哚乙酸)在根系分泌物中的积累(p < 0.01),然而,在番茄根系分泌物中,当浓度为2毫克毫升–1的壳聚糖存在时,这种效果会丧失,这可能是由于高浓度壳聚糖引起的根系系统性损伤所致。

为了评估壳聚糖对植物激素稳态的影响,对根系内源性植物褪黑激素进行了评估,结果显
示,壳聚糖(1毫克毫升–1)导致番茄根细胞中植物褪黑激素的含量略有上升。

壳聚糖诱导根部SA和酚类物质的从头渗出
考虑到使用低剂量的壳聚糖(0.1毫克毫升–1)在10、20和30天内分析根部新生渗出物的结果,我们观察到壳聚糖处理后的根系表现出增加的荧光特征,这被推测为属于水杨酸(SA),壳聚糖显著增加了这些组分的荧光强度,同时也被推测与酚类物质和SA衍生物相关。

在组分1(被假设为芳香族氨基酸和肽)和组分2(被假设为吲哚乙酸)之间虽然差异不显著,但在根系分泌物晚期(30 dap)中,相 对于早期的根系分泌物,荧光强度降低,这可能是由于根系的老化和木质化所导致 ,在这个时期,EEM荧光光谱仅显示两个组分,与对照组没有明显差异。

番茄根系分泌物代谢组学多样性随时间变化
为了建立一个样品池来浓缩根系分泌物并减少样品变异,我们收集了来自20个dap的番茄植物的根系分泌物, 包括壳聚糖处理组和对照组 ,这些根系分泌物显示了大多数NMR峰,这可能是因为较老的植物(30 dap)更加木质化,并且 显示了较少的根际沉积物 。

对于手动策展的根系分泌物样本(包括壳聚糖处理组和对照组),在10、20和30 dap的H NMR谱中观察到没有定性差异,这些谱图分别显示了31、123和18个峰,其中20个峰是特定于20 dap的根系分泌物,值得注意的是,壳聚糖处理降低了在0 dap的根系分泌物中乙酸盐(峰20)的含量(p < 05.53)

壳聚糖处理的植物根系分泌物中果糖-1,6-二磷酸盐的增加可能是由于壳聚糖诱导了ROS的增加,进而导致了根细胞中葡萄糖的额外消耗,壳聚糖处理的植物根系分泌物中甲基腺苷的轻微减少 可能意味着这种聚合物可能会影响根系中的基因表达 。
结论:
壳聚糖会导致番茄根细胞的质膜去极化,进而 促使激素、脂质信号和植物防御化合物(包括酚类物质)的分泌。
这个过程会对细胞活力和根际沉积产生影响,在使用壳聚糖之前,必须考虑植物的年龄以及壳聚糖的应用持续时间。

我们在体内条件下测试了壳聚糖衍生的渗出物,以确定其对根病原体增殖的抑制作用,并进一步减轻疾病的严重程度,我们的研究结果表明,壳聚糖处理植物的根系分泌物能够通过抑制病原体在土壤中的生长来减少其传播, 这表明壳聚糖具有潜力成为一种可持续预防和管理病虫害的制剂。
参考文献:
【1】阿塞米,《壳聚糖与植物生长调节剂:它们对(Burm.f)体外发育影响的比较分析》
【2】沙赫扎德,《壳聚糖与酵母提取物驱动的激发,以增强块茎衍生的癸白癸愈伤组织芳香化合物 2-羟基-4-甲氧基苯甲醛 (2H4MB) 的产生》
【3】Alberts B.,《离子通道和膜的电学性质》
【4】Al-Hetar M. Y.,《壳聚糖对尖孢镰刀菌的抗真菌活性》